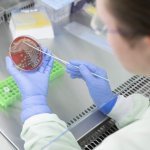

News • Neue Diagnostikplattform
Impflücken und Antibiotikaresistenzen erkennen
Forschende haben eine neue Mikroarray-Plattform entwickelt, die helfen soll, Impflücken aufzudecken und antibiotikaresistente Erreger schneller zu erkennen.
Forschende haben eine neue Mikroarray-Plattform entwickelt, die helfen soll, Impflücken aufzudecken und antibiotikaresistente Erreger schneller zu erkennen.

Prof. Dr. Anna Lena Illert ist seit 1. Oktober 2025 Universitätsprofessorin für Hämatologie und Medizinische Onkologie und neue Direktorin der Klinik für Hämatologie und Medizinische Onkologie der Universitätsmedizin Göttingen (UMG).

Grippeviren mit einem Kaugummi oder Lutscher schnell und einfach nachweisen: Wie das funktionieren kann, zeigen Forschende aus Würzburg, Braunschweig und Köln mit einem neuen Diagnostik-Tool.

Chordome gelten als schwierig zu behandeln, doch Forscher haben jetzt einen neuen Ansatz gegen die seltenen Knochentumoren: Mit maßgeschneiderten Mini-Proteinen soll das Wachstum blockiert werden.

Das Herpes-Simplex-Virus Typ 1 (HSV-1) ist für die Meisten nur unangenehm, für immunschwache Menschen aber durchaus lebensgefährlich. Ein neuentdeckter Antikörper könnte die Infektion verhindern.

Eine weiterentwickelte Form der CAR-T-Zelltherapie soll künftig auch bei soliden Tumoren wie Eierstock- oder Brustkrebs eingesetzt werden. Erste Ergebnisse sind vielversprechend.

Verkehrslärm, Feinstaub, Hitzewellen und Schadstoffe setzen das Herz unter Stress. Vor allem in Kombination erhöhen diese Umweltfaktoren das Gesundheitsrisiko stark, zeigt eine Übersichtsarbeit.

Bereits vermeintlich normale Harnsäure-Werte können ein Risikofaktor für Herz-Kreislauf-Erkrankungen sein – vor allem bei Frauen. Eine neue Studie stellt daher bestehende Grenzwerte in Frage.

Wie schützt das Mikrobiom – die Gesamtheit der Bakterien, Viren und Pilze im Körper – vor Erkrankungen? In einer Studie haben Forschende neue Einblicke in die molekularen Mechanismen gewonnen.

Das NRZ für gramnegative Krankenhauserreger verzeichnet einen erneuten Anstieg multiresistenter Bakterien. Vor allem die Entwicklung beim Reserveantibiotikum Carbapeneme stufen die Experten als bedenklich ein.

Kann das Mikrobiom im Darm von Patienten nach einer Nierentransplantation Hinweise geben, ob das Spenderorgan abgestoßen wird? Eine neue Studie geht diesem Zusammenhang auf den Grund.

Forscher haben ein miniaturisierbares Sensorsystem entwickelt, das die Atemluft effektiv, schnell und preisgünstig auf eine Infektion mit dem Bakterium Helicobacter pylori analysiert.

Um das gesundheitliche Risko, das von einem Tattoo ausgeht, besser einschätzen zu können, haben Forscher erstmals den Weg und den Stoffwechsel der Tätowierfarbe im Körper verfolgt.

Jüngste Ergebnisse von Forschenden der RPTU haben ein bislang unbekanntes metabolisches Hilfsgen in aquatischen Phagen identifiziert und damit das bisherige Verständnis dieser „Bakterienfresser“ erheblich erweitert.

Warum verhalten sich pulmonale Karzinoide bei einigen Patienten gutartig, werden aber bei anderen aggressiv und bilden Metastasen? Forscher gingen der Entwicklung der seltenen Lungentumoren auf den Grund.

Allein in Deutschland leiden rund vier Millionen an einer Herzinsuffizienz. Ein neuer Ansatz zur Behandlung wurde jetzt mit dem Wilhelm P. Winterstein-Preis der Deutschen Herzstiftung ausgezeichnet.

Rätselhaft wie die Sphinx: Ein gestörter Sphingolipid-Stoffwechsel steht mit Erkrankungen wie Ebola, Masern oder Covid-19 in Verbindung. Ein neues Werkzeug soll die Moleküle enträtseln.

Studien deuten darauf hin, dass natürliche Gerinnungshemmer wie Antithrombin III, α1-Antitrypsin und α2-Makroglobulin das Überleben von Covid-19-Patienten verbessern könnten.

Die Alzheimer-Krankheit geht mit der Bildung von Beta-Amyloid-Plaques im Gehirn einher. Neue Forschung zeigt jetzt: Die schädlichen Ablagerungen werden nicht nur von Nervenzellen gebildet.

Diagnose und Überwachung von Krebs, Diabetes, Herz- und Infektionskrankheiten: In diesem Meinungsbeitrag beleuchtet Alix Joseph (Linxens) das Potenzial der Schweißanalyse.

Forscher haben eine vielversprechende Achillesferse Metastasen-bildender Krebszellen gefunden: Sie untersuchen, wie sich der Zelltod-Mechanismus Ferroptose für neue Therapien nutzen lässt.

Die Ursachen der Einschlusskörpermyositis (inclusion body myositis, IBM) sind bislang weitgehend ungeklärt. Entsprechend gibt es keine wirksame Therapie. Eine neue Studie liefert nun neue Erkenntnisse.

Das Epstein-Barr-Virus (EBV) kann schwere Erkrankungen auslösen, darunter auch Krebs. Forscher konnten den Stoffwechsel infizierter Zellen so beeinflussen, dass Folgeerkrankungen reduziert wurden.

Die nichtalkoholische Fettleber ist eine häufige chronische Erkrankung, die schlimmstenfalls zu Leberkrebs führen kann. Neue Forschung zeigt, dass Intervallfasten die Entwicklung aufhalten kann.

Das Verbundprojekt TARGET-MPN untersucht, warum sich myeloproliferative Neoplasien (MPN) zielgerichteter Therapie entziehen und zu Leukämien weiterentwickeln.

Nach einem Schlaganfall oder Herzinfarkt steigt das Risiko für Infektionen – bislang war jedoch kaum bekannt, warum. Forscher fanden nun eine bisher unbekannte Ursache – und einen Therapieansatz.

Forscher haben die molekulare Ursache für die cholämische Nephropathie entdeckt und eine Möglichkeit gefunden, die schädlichen Effekte zu verhindern, die zu der schweren Nierenerkrankung führen.

Auch wenn verschiedene Antibiotika dasselbe Ziel in der bakteriellen Zelle angreifen, können die zellulären Konsequenzen unterschiedlich sein. Das zeigten Mikrobiologen im Rahmen einer neuen Studie.

Der Krankenhauskeim Pseudomonas aeruginosa ist vor allem für immungeschwächte Menschen lebensgefährlich. Forschern gelang es nun, die Pathogenität des Erregers mit einem Enzym zu kontrollieren.

Eine aktuelle Studie lässt mit einem vielversprechenden Ergebnis aus der Tumorforschung aufhorchen: Im Fokus steht ein Enzym, das einen neuen Ansatzpunkt in der Krebsbehandlung eröffnen könnte.

Wissenschaftler haben ein portables Gerät entwickelt, das Enzymwerte nach einer Bauchspeicheldrüsen-Operation in Echtzeit erfasst und so Komplikationen wie die Pankreasfistel verhindern soll.

Für metastasierenden Prostatakrebs gibt es bisher kaum Therapieoptionen. Wissenschaftler haben nun eine Möglichkeit gefunden, um das Ansprechen auf Strahlentherapie und deren Erfolg vorherzusagen.

Tuberkulose ist weltweit die Infektionskrankheit mit den meisten Todesfällen. Forscher haben neuartige, antibiotisch aktive Moleküle identifiziert, die den Erreger weniger gefährlich machen.

Forschende haben einen Mechanismus aufgeklärt, der den Abbau schädlicher Proteinablagerungen fördert. Funktioniert er nicht, kann Parkinson entstehen.

Ein Team der Technischen Universität München (TUM) hat entschlüsselt, was T-Zell-Lymphome zu ihrem schnellen Wachstum verhilft – und wie sich dieses Wissen gegen den Tumor ausnutzen lässt.

Sample throughput: Constant 420 tests / h, up to 626 tests / h with ISEDimensions: 1.050 × 1.150 × 720 mm (w × h × d)Highlights: Large loading capacity: 92 reagent positions, 102 sample positionsHbA1c smart sampling: supports HbA1c onboard hemolysisAdvanced software platform: auto QC, auto reflex, substrate depletion & enzyme linearity extension, etc.Quick…

Highlights:One of the analyses most commonly used is the Enzyme-Linked Immunosorbent Assay (ELISA).With this method, even the smallest concentrations of a range of substances (proteins, peptides, antibodies, hormones etc.) can be detected and quantified from complex solutions.

Fortschritt bei der Behandlung des kutanen Melanoms: Dermatologen der MedUni Wien haben eine neue Option entdeckt, die direkt dort ansetzt, wo die Metastasen entstehen: in den Melanomzellen.

Je dehnbarer die Herzwände, desto besser erfüllt das Herz seine Aufgabe als Pumpe. Forscher aus Münster zeigen nun erstmals, welche Strukturelemente diese Flexibilität wie stark beeinflussen.

Ein bestimmtes Enzym kann dafür sorgen, dass Tumorzellen bei Bauchspeicheldrüsenkrebs resistent gegen Chemotherapie werden, wie ein internationales Forscherteam berichtet.

Forscher haben einen völlig neuen Angriffspunkt für die Behandlung der Akuten Myeloischen Leukämie (AML) identifiziert, eine aggressive Blutkrebsform mit immer noch sehr schlechter Überlebensprognose.

Eine aktuelle Studie untersucht die komplexe Rolle von Lipiden bei der Bildung lebenswichtiger Blutbestandteile. Die Ergebnisse könnten bei der Bekämpfung kardiovaskulärer Erkrankungen von großer Bedeutung sein.

Der "TissueGrinder" soll es Kliniken ermöglichen, auch ohne Hilfe eines ausgebildeten Pathologen die Zellproben von Krebspatienten schnell und präzise zu analysieren.

Einige Erkrankungen wie Multiple Sklerose brechen erst aus, nachdem Immunzellen die Blut-Hirn-Schranke durchbrochen haben. Forscher fanden nun heraus, was dabei passiert.

Eine häufig unentdeckte Antibiotika-Resistenz schneller erkennen: Das ermöglicht ein neues Verfahren, das ein Team der Universitätsmedizin Oldenburg entwickelt hat.

Wenn Brustkrebs in andere Organe streut, ist die Prognose meist schlecht. Forscher entdeckten jetzt einen Prozess, der Brustkrebszellen hilft, sich an bestimmten Stellen im Körper einzunisten.

Die Corona-Pandemie hat viele Auswirkungen auch auf die wissenschaftliche Forschung gehabt – unter anderem hat sie Wissenslücken im Bereich der Gendermedizin aufgezeigt. Immer wieder fielen in Studien als Zufallsbefunde Unterschiede in Morbidität und Mortalität zwischen Frauen und Männern auf. Systematisch untersucht wurden Ausmaß und Ursachen dieser Unterschiede jedoch bislang kaum.

Ein Forschungsteam des Uniklinikums Jena liefert einen Erklärungsansatz dafür, warum Männer im Alter ein höheres Risiko für chronische Nierenerkrankungen haben als Frauen.

Harntreibende Medikamente sind wirksam gegen Bluthochdruck, doch sie erhöhen auch das Risiko, an Diabetes zu erkranken. Forschende aus Bern fanden nun die Ursache dieser Nebenwirkung.

Die Zugabe langkettiger Fettsäuren kann Zellmembranen verdicken und die Aktivität eines Schlüsselenzyms verändern, wie LMU-Wissenschaftler in Zellkulturen zeigen.

Wissenschaftler machen selbst den Methicillin-resistenten Staphylococcus aureus den Garaus.

Wissenschaftler am HZDR haben einen Nanobiosensor entwickelt, der Covid-19-assoziierte Antigene und Antikörper, aber auch andere Biomarker aufspüren soll.

Immunzellen verfügen über einen Backup-Mechanismus, berichten Bonner Forscher: Ist das Enzym TBK1 durch Mutationen gestört, steigt die Anfälligkeit gegenüber Virusinfektionen – außer es fehlt.

Die Regeneration der Leber hängt maßgeblich von den Bakterien im Darm ab, wie Forscher der TUM berichten. Ihre Erkenntnisse könnten dazu beitragen, die Prognosen bei Leber-OPs bei Krebs und anderen Erkrankungen zu verbessern.

Therapien zur Heilung von Hepatitis-B-Virusinfektionen werden dringend gebraucht, doch die Quantifizierung der viralen DNA ist schwierig. Neue Strategien könnten dies ändern.

Seit Ausbruch des Krieges in der Ukraine werden in deutschen Krankenhäusern auffällig viel häufiger bestimmte Krankenhauserreger nachgewiesen, die gegen viele Antibiotika resistent sind.

Wirksame Medikamente gegen chronisch-entzündliche Prozesse sind rar, oder haben starke Nebenwirkungen. Forschende aus Jena stellen jetzt einen vielversprechenden neuen Therapieansatz vor.

Neue Erkenntnisse zum Multiplen Myelom - einer bislang unheilbaren Erkrankung mit kurzer mittlerer Überlebenszeit - könnten bei der Entwicklung neuer Medikamenten helfen.

Trotz Chemo- oder Strahlentherapie überleben BRCA1/2-mutierte Tumorzellen oft. Es gelingt ihnen, therapiebedingte DNA-Schäden zu reparieren. Wie eine Blockade des Proteins TSG101 sie daran hindert, darüber berichtet ein Team um Claus Scheidereit vom Max Delbrück Center.

Viele Tumoren sind wegen ihres hochaktiven Stoffwechsels anfällig gegenüber einer speziellen Art des Zelltods, der Ferroptose. Dennoch gelingt es Krebszellen häufig, diesem Schicksal zu entgehen. Wissenschaftlerinnen und Wissenschaftler im Deutschen Krebsforschungszentrum entdeckten nun einen neuen Mechanismus, mit dem sich normale wie auch Krebszellen vor der Ferroptose schützen. Die…

Da sie oft schlecht an die Blutversorgung angeschlossen sind, leiden Krebszellen häufig unter Nährstoffmangel. DKFZ-Forscher entdeckten nun, wie sie unter diesen Bedingungen ihr Überleben sichern.

Das Antidepressivum Fluoxetin hemmt SARS-CoV-2 in Zellkulturen und in Präparaten aus menschlichem Lungengewebe. Nach aufwändigen vergleichenden Studien steht nun fest, wie das passiert.

Ein spezielles Hydrogel verbessert die Haltbarkeit von Impfstoffen auch ohne Kühlung massiv verbessert. Die Erfindung könnte Leben retten und die Kosten von Kühlketten senken.

Norwegische Forscher haben eine Methode zur Früherkennung von Krankheiten entdeckt, bei der Enzyme gezielt durch Erbkrankheiten geschädigte Proteine reparieren.

Manche Lungentumore sprechen nicht auf die Strahlentherapie an. Dieser Effekt kann durch die Blockade eines Enzyms in den Tumorzellen aufgehoben werden, wie ein Würzburger Forschungsteam berichtet.

Ein Forschungsteam hat herausgefunden, über welche Mechanismen das Coronavirus das Herz befällt – und wie es aufgehalten werden könnte.

Ursachen für Intelligenzminderung oder Epilepsie bleiben bei mehr als 50 Prozent der Betroffenen bislang ungeklärt. Forschende haben zwei Gene mit Mutationen entdeckt, die Ursachen für neurologische Entwicklungsstörungen bei Kindern sind.

Neueste Entwicklungen im computergestützten Proteindesign erlauben es, Sequenz- und Strukturänderungen von Proteinmolekülen zu simulieren, um neuartige Wirkstoffe in der Humanmedizin zu entwickeln. Genau dieser Vorstoß ist jetzt Wissenschaftlern am Max-Planck-Institut für Biologie in Tübingen gelungen.

Forschende haben den Resistenzmechanismus gegen ein Leukämie-Medikament aufgeklärt – und finden einen Ausweg um einer medikamentösen Behandlung zum Erfolg zu verhelfen.

Forschende haben die Struktur eines wichtigen Enzyms im Stoffwechsel des Krankenhauskeims Acinetobacter baumannii aufgeklärt.

Forschende haben 300 Tage nach einer Coronavirus-Infektion mit der ursprünglichen Variante hohe Mengen neutralisierender Antikörper in ProbandInnen nachweisen können.

Forscher haben einen Mechanismus entdeckt, der das Multiple Myelom, unempfindlich gegen Therapien machen kann. Das könnte zu neuen Behandlungen des Knochenmarkkrebses führen.

Ein aus einem bio-basierten Werkstoff entwickeltes neuartiges Sensormaterial könnte eine enzymfreie Messung der Glukosekonzentration im Blut ermöglichen.

Forschende haben einen Mechanismus entdeckt, der für Herzrhythmusstörungen bei Herzschwäche verantwortlich ist. Im nächsten Schritt soll dieser direkt blockiert werden können, um die Überlebenschancen der Betroffenen deutlich zu verbessern.

Wissenschaftler haben einen Algorithmus veröffentlicht, der Krebstreiber sowohl in den proteinkodierenden als auch in den nicht-kodierenden Bereichen des Erbguts aufspürt.

Bis zu 3000 Komponenten kann das Gift einer einzigen Spinne enthalten. Aus den Bestandteilen lassen sich vielversprechende Wirkstoffkandidaten für die Behandlung von Krankheiten entwickeln.

Eine besonders aktive Form von Immunzellen steht im Verdacht, schwere Covid-Verläufe auszulösen. Die CD16-positiven T-Zellen wirken verstärkt zytotoxisch, etwa im Inneren von Blutgefäßen.

mRNA-Nanopartikel spielen im Covid-19-Impfstoff der Firmen BioNTech und Pfizer eine wichtige Rolle. Forscher haben jetzt einen Weg gefunden, die Teilchen noch wirksamer zu machen.

Forscher der Friedrich-Alexander-Universität Erlangen-Nürnberg (FAU) untersuchen, wie aktive DNA-Moleküle mit therapeutischem Potenzial funktionieren.

Forschende haben einen bisher unbekannten Signalweg aufgedeckt, der die T-Zellen des Immunsystems lange am Leben erhält. Das könnte der altersbedingten Abnahme der Abwehrhelfer entgegenwirken.

Dank einer bisher einzigartigen weltweiten Zusammenarbeit gab es sehr schnell Impfstoffe gegen SARS-CoV-2. Bei der Entwicklung von Medikamenten gegen Covid-19 gab es bisher aber nur Teilerfolge. Gefördert von der Bayerischen Forschungsstiftung hat nun ein Münchener Forschungsteam ein Protein entwickelt, das im Zellversuch die Infektion durch das Virus und seine Varianten zuverlässig verhindert.

Das Screening von Neugeborenen auf Immun-, Hormon- und Stoffwechselstörungen hat seit seiner Einführung vor rund 60 Jahren viele Menschen vor schweren Krankheitsverläufen bewahrt. Die Möglichkeiten der systematischen Frühtests sind durch Einsatz der Massenspektrometrie (MS) erheblich erweitert worden.

Das Hautbakterium Staphylococcus aureus entwickelt oft Antibiotika-Resistenzen. Es kann dann schwer zu behandelnde Infektionen verursachen. Forschende der Universität Bonn haben aufgeklärt, wie raffiniert sich ein bestimmter Staphylococcus aureus-Stamm gegen das wichtige Antibiotikum Vancomycin schützt. Die Ergebnisse sind nun in der Fachzeitschrift Microbiology Spectrum erschienen.

Pockenviren haben einen einzigartigen Weg gefunden, ihre Gene im infizierten Organismus in Proteine zu übersetzen.

Bakterien, die gegen viele Antibiotika resistent sind, sind besonders für Menschen, die im Krankenhaus behandelt werden, eine große Gefahr. Seit 2009 sammelt das Nationale Referenzzentrum (NRZ) für gramnegative Krankenhauserreger in der Abteilung für Medizinische Mikrobiologie der Ruhr-Universität Bochum (RUB) deutschlandweit Daten über solche Bakterien.

Die nicht-alkoholische Fettlebererkrankung (NAFLD) ist die häufigste Lebererkrankung in den westlichen Ländern mit weltweit steigender Inzidenz. Folgen einer NAFLD können auch Nierenerkrankungen und Nierensteine sein, wobei die Mechanismen zur Entwicklung dieser Nierenleiden auf Grund von NAFLD noch nicht vollständig aufgeklärt sind. Forschende des Leibniz-Instituts für Arbeitsforschung an…

Woher zieht ein bösartiger Tumor die Energie, die er braucht, um immer weiter wachsen zu können? Das ist eine zentrale Frage der Krebsforschung. Denn: Kennt man die Energiequelle, könnte man dem Tumor vielleicht die Zufuhr abschneiden, ihn sozusagen „aushungern“. Die Grundlagen genau dafür haben jetzt Forscher und Mediziner der Technischen Universität München (TUM) am…

Eine neue Kombination zweier antimikrobieller Substanzen galt als Hoffnungsträger für die Behandlung von Infektionen durch Enterobakterien – doch eine aktuelle Studie an der Justus-Liebig-Universität (JLU) und dem Deutschen Zentrum für Infektionsforschung (DZIF) machte diese Hoffnung nun zunichte. Schon vor dem Einsatz der Substanzen in Deutschland fanden die Wissenschaftler Bakterien,…

Auf therapeutischen Antikörpern ruht eine große Hoffnung der Krebstherapie. Forschende der TU Darmstadt und der Firma Merck haben einen Weg gefunden, Antikörper erst am Tumor selbst zu aktivieren. So werden unerwünschte Nebenwirkungen in gesundem Gewebe vermieden. Die Ergebnisse der Forschung wurden in der Fachzeitschrift „Frontiers in Immunology“ veröffentlicht.

Gesunde Haut verfügt über einen bakteriellen Schutzschild gegen Krankheitserreger: das Mikrobiom. Dessen Zusammensetzung galt bisher als schwer zu entschlüsseln. Einem Forschungsteam ist es jetzt gelungen, mit Hilfe des Enzyms Benzonase die lebendigen Bakterien in Abstrichen der Haut durch Sequenzierung zu identifizieren. Die Methode eröffnet neue Möglichkeiten der Diagnose und Therapie für…

Ein Team unter der Leitung von Forschern des Wiener IMBA (Institut für Molekulare Biotechnologie der Österreichischen Akademie der Wissenschaften) hat möglicherweise die Achillesferse des Coronavirus gefunden: Zwei zuckerbindende Proteine behindern SARS-CoV-2-Varianten am Eindringen. Die Ergebnisse, die das Potenzial für variantenübergreifende Therapien haben, wurden jetzt im EMBO Journal…

Im Labor Gewebe herzustellen, mit denen sich geschädigte Organe heilen oder ersetzen lassen, ist eine der großen Zukunftsvisionen der Medizin. Künstliche Materialien könnten sich als Gewebegerüste eignen, denn anders als natürliches Gewebe bleiben sie im Organismus lange genug stabil, so dass der Körper neue natürliche Strukturen ausbilden kann. Eine grundlegende Voraussetzung für…

Bisher gibt es gegen die meisten Virus-Infektionen keine wirksamen Gegenmittel. Ein interdisziplinäres Forschungsteam der Technischen Universität München (TUM) hat nun eine neue Strategie entwickelt: Mit der Methode des DNA-Origami aus Erbgut-Material maßgeschneiderte Nano-Kapseln schließen Viren ein und machen sie so unschädlich. Die Strategie wurde bereits gegen Hepatitis- und…

Eine neue Gesichtsmaske von Forschern des Massachusetts Institute of Technology (MIT) und der Harvard University erkennt eine Covid-19-Infektion mithilfe eingebetteter Sensoren. Den Ingenieuren zufolge schlägt der Prototyp bei einem positiven Träger binnen 90 Minuten zuverlässig Alarm. Die Sensor-Technologie könnte auch zur Herstellung von Kleidung verwendet werden, die zahlreiche…

Lungenkrebs ist nicht gleich Lungenkrebs. Jeder Tumor bringt seine individuellen genetischen Eigenschaften mit sich, sagt Prof. Dr. Gernot Rohde im Rahmen des 61. Kongresses der Deutschen Gesellschaft für Pneumologie und Beatmungsmedizin (DGP).

Das Enzym PRMT1 zeigt an, wie gut die Überlebenschancen für Patienten stehen, die an Bauchspeicheldrüsenkrebs erkrankt sind. Das haben die Teams um die Marburger Molekularbiologieprofessorin Dr. Uta-Maria Bauer und den Marburger Medizinprofessor Dr. Detlef Bartsch herausgefunden, indem sie Erkenntnisse aus der molekularen Grundlagenforschung und der klinischen Forschung zusammenführten.

Das Hormon Prolaktin ist nicht nur für das Wachstum und die Entwicklung der weiblichen Brüste sowie die Produktion von Milch während der Schwangerschaft verantwortlich. Es trägt auch zur Entwicklung von Brustkrebs bei. Zusätzlich könnte das Hormon die Erforschung zielgerichteter Medikamente gegen multiple Formen der Krankheit ermöglichen, wie zwei Studien des VCU Massey Cancer Center…

Höhergradige Gliome haben nach wie vor keine gute Prognose. Zwei wegweisende klinische Studien mit unterschiedlichen, innovativen immunologischen Therapiekonzepten wurden kürzlich in hochrangigen Fachzeitschriften publiziert. So wurden in der Neuroonkologie der Universität Heidelberg und Mannheim erstmals über 30 erwachsene Patienten mit einem mutationsspezifischen „Krebsimpfstoff“…

Eine Infektion mit parasitischen Eingeweidewürmern, sogenannten Helminthen, kann augenscheinlich dafür sorgen, dass virale Infektionen anderswo im Körper erheblich schwerwiegender verlaufen. Das zeigt eine Studie unter Federführung der Universitäten Kapstadt und Bonn. Demnach entwickelten Helminthen-befallene Mäuse nach einer Infektion mit Genital-Herpesviren deutlich gravierendere…

Tumorimpfungen können den Körper im Kampf gegen Krebs unterstützen. Mutationen im Tumorerbgut führen häufig zu krebstypisch veränderten Proteinen. Ein Impfstoff kann das Immunsystem der Patienten auf solche mutierten Proteine aufmerksam machen. Mediziner und Krebsforscher aus Heidelberg und Mannheim haben nun erstmals einen mutationsspezifischen Impfstoff gegen bösartige Hirntumoren in…

Krebszellen haben Mechanismen entwickelt, um der körpereigenen Immunabwehr zu entkommen. Wirkstoffe, die das unterbinden können, sind attraktive Ziele in der Entwicklung neuer Krebstherapien. Eine Forschungsgruppe am Max-Planck-Institut für molekulare Physiologie (MPI) in Dortmund hat ein neuartiges Testsystem zur Suche nach immunregulatorischen Substanzen in Zellen entwickelt, mit dem eine…

Ein Forschungsteam von Pharmazeuten der Universität Bonn hat zwei Wirkstoff-Familien entdeckt, die die Vermehrung des Coronavirus SARS-CoV-2 blockieren können. Die Arzneimittelkandidaten scheinen geeignet, das Schlüsselenzym des Virus, die sogenannte Hauptprotease auszuschalten. Die Studie basiert auf Laborexperimenten. Für die Entwicklung von Medikamenten sind noch aufwändige klinische…

Zum Rare Disease Day, dem Tag der seltenen Erkrankungen, der seit 2008 jedes Jahr am letzten Tag im Februar stattfindet, weist die Deutsche Leberstiftung auf seltene Erkrankungen hin, die insgesamt recht häufig sind. Viele von ihnen können auch zu einer Leberschädigung führen. Inzwischen gibt es für etliche Erkrankungen Behandlungsmöglichkeiten – deshalb ist die entsprechende Diagnose…

Ein langer, steiniger Weg zur Diagnose und dann kaum Therapien oder Medikamente, die helfen können – so sieht oftmals das Leben von Patienten mit einer Seltenen Erkrankung aus. Die Erkrankungsgruppe der autosomal-rezessiven cerebellären Ataxie, kurz ARCA, gehört dazu. Nur rund drei bis sechs von 100.000 Personen leiden in Deutschland an dieser Erbkrankheit, die auf den zunehmenden Verlust…

Eine präklinische Studie am Universitätsklinikum Tübingen zeigt erfolgsversprechende Effekte eines neuen Therapieansatzes bei durch nicht-alkoholischer Steatohepatitis (NASH) hervorgerufenem Leberzellkarzinom (HCC). Der als „induzierte Lipotoxizität“ bezeichnete Vorgang zielt darauf ab, Therapieresistenzen beim Leberzellkarzinom zu überwinden. Die neue Studie ist im Wissenschaftsjournal…

Die Atherosklerose, umgangssprachlich Arterienverkalkung genannt, ist die Hauptursache von Schlaganfall und Herzinfarkt. Münchner Forscher der Technischen Universität München (TUM) und des LMU Klinikums haben jetzt mit einem internationalen Team neuartige synthetische Peptide entwickelt, die die Atherosklerose in vitro, also im Reagenzglas, und im Tiermodell hemmen.

Mit zwei marktverfügbaren Hemmstoffen lässt sich bei Neuroblastomen der Zellzyklus der Krebszellen an einer Schlüsselstelle so stören, dass die Tumorzellen sterben. Neuroblastome sind bösartige solide Tumoren, die vor allem im frühen Kindesalter auftreten. Sie entstehen aus entarteten unreifen Zellen des sympathischen Nervensystems. Ein Anhaltspunkt, mit dem sich die Bösartigkeit des…

Die altersbedingte trockene Makuladegeneration (AMD) ist eine Augenerkrankung, die zum Verlust des Sehvermögens führt und an der ca. 7,4 Millionen Menschen in Deutschland leiden. Forschende des Paul-Ehrlich-Instituts haben in einem internationalen Forschungsverbund einen grundlegenden Mechanismus aufgeklärt, der über die Aktivierung im Genom vorhandener mobiler genetischer Elemente…

Um die Anwendung von Corona-Tests zu vereinfachen, hat das Mannheimer Unternehmen Pharmact den BELMONITOR LAB COV-2 entwickelt – einen Antigentest, der eine Infektion anhand von Gurgeln und einem Abstrich im vorderen Nasenbereich detektiert. Im Gegensatz zu anderen Antigentests erfordert er keinen unangenehmen Rachenabstrich.

Eine Störung der Blutbildung – eine B-Zell-Lymphozytose – führt in einigen Fällen zu Blutkrebs. Doch die epigenetische Signaturen beider Erkrankungen gleichen sich und bilden sich sehr früh. Dies zeigte nun ein internationales Team mit Hilfe von Proben von Betroffenen. Chronische Leukämien beginnen häufig schleichend. Erst nach und nach breiten sich weiße Blutzellen oder ihre…

Die Suche nach wirksamen antiviralen Mitteln gegen das neue Coronavirus läuft auf Hochtouren. Mit einem neuartigen Ansatz haben Tübinger Bioinformatiker nun eine Schwachstelle des Virus entdeckt, die für die Wirkstoffentwicklung genutzt werden könnte. In einem Computermodell identifizierte der DZIF-Wissenschaftler Andreas Dräger und sein Team ein menschliches Enzym, das für das Virus…

Darmkrebsstammzellen haben einen wunden Punkt: das Enzym Mll1. Wird es blockiert, entstehen keine neuen Tumore im Körper. Dies hat nun ein MDC-Team um Walter Birchmeier in Nature Communications gezeigt. Seitdem in Deutschland die Darmspiegelung zur Krebsfrüherkennung eingeführt wurde, sank die Zahl der jährlichen Krebsdiagnosen im fortgeschrittenen Stadium. Denn Krebsvorstufen können nun…

Ein neu entwickelter Wirkstoff lässt Krebszellen aushungern, indem er ihre „Kraftwerke“ - die sogenannten Mitochondrien - angreift. Der neue Wirkstoff verhindert das Ablesen der genetischen Information der Mitochondrien. Wissenschaftler des Max-Planck-Instituts für Biologie des Alterns, des Stockholmer Karolinska Instituts und der Universität Göteborg berichten in ihrer in der…

Das Deutsche Zentrum für Neurodegenerative Erkrankungen (DZNE) erhält von der US-amerikanischen Initiative „Aligning Science Across Parkinson’s“ (ASAP) drei Millionen US-Dollar an Forschungsförderung. Die Mittel gehen zu gleichen Teilen an die DZNE-Standorte in Bonn und Tübingen.

Mit neuen Biosensoren sind Forscher der Universität Innsbruck in der Lage, die Aktivität von Kinasen direkt in intakten Zellen zu bestimmen. Nun haben die Grundlagenforscher um Eduard Stefan diese Technologie weiterentwickelt, um vorhersagen zu können, ob Medikamente bestimmte Kinasen, deren Mutationen Krebserkrankungen auslösen können, hemmen.

Bei einer Reihe von Erkrankungen stehen miteinander verklebte Eiweißbausteine, sogenannte Fibrillen, als Verursacher in dringendem Verdacht. Ein Team von Biophysikern der Heinrich-Heine-Universität Düsseldorf (HHU) und des Forschungszentrums Jülich hat sich damit beschäftigt, wie das Wachstum dieser pathogenen Fibrillen gehemmt werden kann. In einer kürzlich erschienen…

Seit über zehn Monaten hält die Corona-Pandemie die Welt nun schon in Atem. Obwohl die meisten Länder umfangreiche Schutzmaßnahmen in die Wege geleitet haben, steigen die Infektions- und Todesraten. Angesichts der bislang nur wenigen Therapieoptionen beschränken sich Forscher bei der Suche nach einem sicheren, effektiven und global verfügbaren Gegenmittel für COVID-19 nicht auf die Suche…

Dass ein übermäßiger Verzehr von rotem Fleisch das Risiko erhöht, an Darmkrebs zu erkranken, ist bekannt. Die organische Verbindung „Häm-Eisen“ steht im Verdacht, für die krebsfördernde Wirkung verantwortlich zu sein. Einem Forscherteam der TU Kaiserslautern um Professor Jörg Fahrer ist es jetzt gelungen, die toxische Wirkung von Häm-Eisen in gesunden Darmzellen zu beschreiben. Dabei…

Infektionen mit Bakterien und Viren sind eine zusätzliche Belastung für das Herz-Kreislauf-System. Das gilt auch für das Coronavirus SARS-CoV-2. Doch das Virus scheint nicht nur bei älteren Menschen mit kardiovaskulären Grunderkrankungen zu Herzschädigungen zu führen. Auch nur leicht erkrankte, jüngere Patienten können nach überstandener COVID-19-Infektion entzündliche Veränderungen…

Forscher haben zelluläre Faktoren untersucht, die für eine Infektion von Bedeutung sein könnten. Sie analysierten dazu die Aktivität von 28 spezifischen Genen in einer Vielzahl menschlicher Gewebe.

Forscher haben den molekularen Mechanismus aufgeklärt, mit dem sich Bakterien an Zellulosefasern im Darm anheften. Indem sie auf zwei verschiedene Arten an die Fasern binden, können sie den Schwerkräften im menschlichen Körper standhalten.

Dringen Krankheitserreger in unseren Körper ein, löst das eine Reihe von Reaktionen aus: Das Immunsystem wird aktiv und beginnt den Eindringling zu bekämpfen. Dabei sind unter anderem Makrophagen, also Fresszellen, beteiligt. Sie nehmen den pathogenen Erreger auf und töten ihn. Ein internationales Forschungsteam aus Jena, Großbritannien, Portugal, Griechenland und den USA konnte nun…

Eine angeborene Störung des Fettstoffwechsels kann augenscheinlich zu einer chronischen Überreaktion des Immunsystems führen. Zu diesem Schluss kommen Forscher der Universität Bonn in einer neuen Studie. Die Ergebnisse erscheinen in der Zeitschrift Autophagy. Bei manchen Menschen sorgt ein Gendefekt dafür, dass ihre Zellen eine ungewöhnliche Form von Fetten bilden. Die Folgen dieser sehr…

Der Mensch lebt in Symbiose mit einer Vielzahl von Mikroorganismen, die sowohl in seiner Umgebung, wie auch auf und in seinem Körper zu finden sind. Welch wichtige Funktion sie beim Menschen haben, wurde bis vor wenigen Jahren unterschätzt.

Das Team von Neurobiologin Prof. Dr. Claire Jacob hat einen wichtigen Mechanismus aufgedeckt, der die Wiederherstellung der Myelinhülle nach einer Verletzung durch ein Trauma oder eine degenerative Erkrankung reguliert. Basierend auf diesen Erkenntnissen wurden geschädigte Myelinscheiden bei Mäusen durch die Behandlung mit dem Wirkstoff Theophyllin regeneriert und so die Funktion der…

Das Coronavirus SARS-CoV-2 hat bis Mitte 2020 weltweit mehr als 600.000 Tote gefordert. Die Prozesse im Körper, die eine Infektion mit SARS-CoV-2 so gefährlich werden lassen, sind bislang nicht vollständig geklärt. Ein Forscherteam der FAU Erlangen-Nürnberg um Dr. Moritz Leppkes, Oberarzt der Medizinischen Klinik 1 – Gastroenterologie, Pneumologie und Endokrinologie des…

Forscher zeigen, dass das AIDS-Virus HIV-1 dank einer ausgeklügelten Vermehrungsstrategie nur minimale Aufmerksamkeit in infizierten Zellen erregt, so dass die Infektion zumindest in T-Zellen, die selbst Bestandteil des Immunsystems sind, weitgehend unbemerkt abläuft.

Die Abteilung Infektionsbiologie des Deutschen Primatenzentrums (DPZ) – Leibniz-Institut für Primatenforschung in Göttingen konnte zusammen mit Kollegen an der Charité in Berlin zeigen, dass das Malaria-Medikament Chloroquin eine Infektion von menschlichen Lungenzellen mit dem neuartigen Coronavirus nicht verhindert.

An der Entstehung einer chronischen Bauchspeicheldrüsenentzündung (Pankreatitis) sind Mutationen in einem Ionenkanal in der Zellmembran beteiligt, der eine spezifische Durchlässigkeit für Kalziumionen besitzt. Diese bahnbrechende Entdeckung machte ein Forschungsteam der Technischen Universität München (TUM) zusammen mit weiteren Gruppen aus Deutschland, Japan und Frankreich. Damit könnten…

Mikrogen GmbH, ein Unternehmen, das gentechnisch hergestellte in vitro Diagnostika entwickelt, hat heute die CE-Kennzeichnung seines recomWell SARS-CoV-2 IgG-Tests bekannt gegeben. Der Test erlaubt medizinischen Diagnostiklabors den Nachweis von Antikörpern gegen das neue SARS-CoV-2 Coronavirus in Blutproben von Patienten auf gängigen ELISA-Systemen. Damit adressiert der Test einen derzeitigen…

Die akute myeloische Leukämie (AML) ist eine aggressive Form von Blutkrebs, die Kinder und Erwachsene betrifft. In Fällen mit besonders schlechter Prognose wird dieser Krebs durch onkogene Fusionsproteine ausgelöst, an deren Bildung das Gen Nucleoporin 98 (NUP98) beteiligt ist. Eine soeben in der Fachzeitschrift „Blood“ veröffentlichte Studie der Vetmeduni Vienna präsentiert nun einen…

Das SARS-Coronavirus 2 (SARS-CoV-2) infiziert Lungenzellen und ist für die Covid-19-Pandemie verantwortlich. Das sogenannte Spike-Protein dient dem Virus als Schlüssel zur Wirtszelle und trägt eine ungewöhnliche Aktivierungssequenz.

VRAC/LRRC8 Chlorid-Kanäle spielen nicht nur beim Transport von Zytostatika, Aminosäuren und Neurotransmitter eine entscheidende Rolle. Sie können auch den wichtigen Botenstoff cGAMP von Zelle zu Zelle transportieren und damit eine Immunantwort bei Infektionen mit DNA-Viren verstärken.

Mit einem einfachen Speicheltest kann jeder selbst zu Hause feststellen, wie fit sein orales Immunsystem ist. Besonders Menschen mit Diabetes leiden unter einer oft unbemerkten Parodontitis. Diese schwächt das Immunsystem, so dass es Bakterien und Viren leichter gelingt, in den Körper einzudringen.

Ein internationales Forscherteam unter Federführung der Universitäten Bonn und Ulm hat untersucht, wie sich ein zelleigener „Protein-Schredder“ gezielt zum Kampf gegen Krebs programmieren lässt. In ihrer Studie konnten die Wissenschaftler den Abbau von Proteinen nachweisen, die zum Beispiel bei Brustkrebs übermäßig aktiv sind. Die Ergebnisse sind in der Fachzeitschrift „Chemical…

SARS-CoV-2 ist hochansteckend und kann schwere Lungenentzündung mit Atemnot (COVID-19) verursachen. Weltweit sucht die medizinische Forschung nach Möglichkeiten, wie man die Vermehrung der Viren mithilfe von Medikamenten verhindern kann. Ein Team der Universität Lübeck hat dafür einen vielversprechenden Ansatz gefunden. Mithilfe des hochintensiven Röntgenlichts der Berliner…

Eine Immunreaktion im Gehirn scheint für die Entwicklung der Alzheimer-Erkrankung maßgeblich mitverantwortlich zu sein. Sie gießt gewissermaßen „Öl ins Feuer“ und sorgt so augenscheinlich für eine Entzündung, die sich gewissermaßen selbst immer weiter anfacht. Die Studie ist nun in der Zeitschrift „Cell Reports“ erschienen. Charakteristisch für die Alzheimer-Erkrankung sind…

Um eine Krankheit auszulösen, müssen Viren in Körperzellen eindringen. Dazu heften sie sich an geeignete Zellen an und schleusen ihre Erbinformation in diese Zellen ein. Infektionsforscher vom Deutschen Primatenzentrum – Leibniz-Institut für Primatenforschung in Göttingen haben zusammen mit DZIF-Wissenschaftlern von der Charité – Universitätsmedizin Berlin untersucht, wie das neuartige…

Wissenschaftler vom Deutschen Krebsforschungszentrum (DKFZ) und von der Hebrew University in Jerusalem zeigten bei Mäusen: Darmbakterien programmieren in Zellen der Darmschleimhaut die Aktivität des Erbguts um und nehmen damit erheblichen Einfluss auf die Entwicklung des gesunden Darms. Eine experimentell hervorgerufene akute Darmentzündung führte in den Schleimhautzellen der keimbesiedelten…

Während in der Elektrotechnik die Miniaturisierung schon weit vorangeschritten ist, füllt die Analyse- und Prozesstechnik in Medizin und Biochemie heute noch ganze Labore. Forschende der Universität Stuttgart und des Center for Free-Electron Laser Science (CFEL) in Hamburg haben nun eine Methode entwickelt, mit der sich ein Labor auf die Größe einer Nadelspitze miniaturisieren lässt. Sie…

Wissenschaftler des Universitätsklinikums Carl Gustav Carus Dresden im Nationalen Centrum für Tumorerkrankungen Dresden (NCT/UCC) haben gemeinsam mit einem internationalen Forscherteam in Laborversuchen einen bislang unbekannten Überlebensmechanismus im Zellkern besonders aggressiver Tumorzellen entschlüsselt. Eine wichtige Rolle hierbei spielt das proteinspaltende Enzym Caspase 8, das sich…

Sterbende Körperzellen können das Immunsystem in Schach halten und verhindern so unerwünschte Immunreaktionen gegen den eigenen Körper. Wissenschaftler vom Deutschen Krebsforschungszentrum haben jetzt einen Rezeptor auf Immunzellen identifiziert, der diesen Schutzmechanismus aktiviert. So werden gefährliche Autoimmunreaktionen verhindert, bei denen sich das Abwehrsystem gegen körpereigene…

Paradoxerweise kann der viel verwendete Gerinnungshemmer Heparin bei einigen Patienten zur Bildung von Blutgerinnseln führen. Mediziner der Ludwig-Maximilians-Universität München (LMU) haben nun gezeigt, dass die Hemmung eines bestimmten Enzyms dieses Risiko vermindern könnte. Heparin wird häufig verwendet zur postoperativen Prophylaxe von Beinvenenthrombosen, zur Therapie von venösen…

So wie Wale während ihres Fressvorgangs Unmengen an Wasser aufnehmen und dann ihre Nahrung herausfiltern, nehmen auch Fresszellen des Immunsystems große Mengen an Gewebsflüssigkeit auf, um diese anschließend in zellinneren Bläschen, den Vakuolen, zu filtern. Im Rahmen dieser Filtration muss es der Zelle gelingen, gewaltige Mengen an Wasser wieder abzugeben, den Inhalt der Vakuolen zu…

Mit einem speziellen 3D-Drucker lebendiges Knochengewebe für komplexe Operationen herstellen: Daran forscht ein Team um Prof. Dr. Günter Finkenzeller, Forschungssektionsleiter an der Klinik für Plastische und Handchirurgie des Universitätsklinikums Freiburg, und Dr. Peter Koltay, leitender Wissenschaftler am Institut für Mikrosystemtechnik der Universität Freiburg.

Entzündungsvorgänge treiben die Entwicklung neurodegenerativer Hirnerkrankungen voran und sind maßgeblich dafür verantwortlich, dass sich in den Nervenzellen sogenannte Tau-Proteine anhäufen. Zu diesem Schluss kommt ein internationales Forschungsteam unter der Federführung des Deutschen Zentrums für Neurodegenerative Erkrankungen (DZNE) und der Universität Bonn im Fachjournal…

Anfang 2019 startete das EU-Projekt ELSAH mit dem Ziel, innerhalb von vier Jahren ein Wearable zu gestalten, das eine kontinuierliche Bestimmung der Konzentration von Biomarkern ermöglicht. Im Interview erklärt Projektkoordinator Dr. Joerg Schotter die Ziele des Projekts und die potenziellen Anwendungsbereiche für das geplante Wearable.

Noch immer sind Antibiotika die wichtigste Waffe zur Bekämpfung bakterieller Infektionen. Jedoch geht der Medizin aufgrund von immer häufiger vorkommenden Resistenzen die „Munition“ aus. Ein Forschungsteam hat nun die Struktur des proteinabbauenden Komplexes ClpX-ClpP aufgeklärt. Dies ist ein Schlüssel zur Entwicklung innovativer Antibiotika, die auf den Abbauprozess von defekten…

Verletzungen von Nervenfasern an Gehirn, Rückenmark und Sehnerven haben in der Regel funktionelle Verluste zur Folge, weil die Nervenfasern nicht regenerationsfähig sind. Ein Team des Lehrstuhls Zellphysiologie der Ruhr-Universität Bochum (RUB) um Prof. Dr. Dietmar Fischer hat neue Mechanismen entschlüsselt, die die Regeneration solcher Fasern ermöglichen. Das könnte neue Therapieansätze…

Biomarker gelten bei Alzheimer als gute diagnostische Indikatoren. Wissenschaftler der Medizinischen Fakultät der UDE und des UK Essen haben daher nach einem neuen Biomarker gesucht, der schon im Blut leicht nachgewiesen werden kann und damit weniger kostspielig ist. Dabei sind die Forscher auf Kallikrein-8 (KLK8) gestoßen. Das Enzym ist an der Gedächtnisbildung und Angstentstehung beteiligt.…

Tätowieren könnte auch diagnostisch interessant werden. Ein Wissenschaftlerteam aus Deutschland hat Tattoos entwickelt, die eigentlich krankheitsanzeigende Sensoren sind. Die Forscher injizierten sie anstelle von Tattoofarbe eine Lösung aus chemischen Sensoren in die Haut. Auf den tätowierten Hautbereichen war bei Veränderungen des pH-Werts oder der Konzentration von verschiedenen…

Das Thema Wundinfektionen ist im Bereich der Krankenhausversorgungen und der ambulanten Betreuung von Patienten ein bekanntes und kostenintensives Problem. Durch die Ausbreitung von antibiotikaresistenten Bakterien wird diese Situation weiter verschärft. Verfügbare Budgets können die Kosten für derartige Behandlungen meist nicht vollständig decken. In diesem Zusammenhang haben…

Bei seltenen, erblichen Speichererkrankungen wie der Sandhoff-Krankheit oder dem Tay-Sachs-Syndrom kann in den Nervenzellen der Stoffwechselmüll von auflaufenden Gangliosiden nicht richtig entsorgt werden, weil wichtige Enzyme fehlen. Die Folgen für die Patienten sind gravierend: von Bewegungseinschränkungen über Erblindung und geistigen Verfall bis hin zum frühen Tod. Wissenschaftler der…

Augenärzte des Klinikums der Ludwig-Maximilians-Universität haben als erstes Zentrum in Deutschland die erste zugelassene Gentherapie zur Behandlung einer erblich bedingten Netzhauterkrankung eingesetzt.

Forscher des Universitätsklinikums Freiburg und der Albert-Ludwigs-Universität Freiburg haben eine neue Möglichkeit entdeckt, um das Wachstum von Prostatakrebszellen zu blockieren, bei denen bislang etablierte Therapien nicht mehr wirken. Die Freiburger Forscher entschlüsselten die Struktur und den Wirkmechanismus des Enzyms KMT9, das zur Gruppe der Histon-Methyltransferasen gehört. Diese…

Wissenschaftler der TU Dresden entwickeln ein Biofiltersystem auf der Basis von Pilzenzymen, das kritische Chemikalien effektiv und nachhaltig aus gereinigtem Abwasser entfernt. Die Arbeitsgruppe Enzymtechnik am Institut für Naturstofftechnik forscht seit zwei Jahren an dem biochemischen Verfahren zur Entfernung von Xenobiotika, die Flüsse und Seen belasten. Xenobiotika – dazu gehören…

Mit der zunehmenden Antibiotika-Resistenz werden alternative Verfahren zur Behandlung bakterieller Infektionen immer notwendiger. Forschenden der Universität Greifswald ist es in Zusammenarbeit mit der Universität Münster gelungen, Zielzellen pathogener Bakterien enzymatisch so vorzubehandeln, dass eine bedeutende toxische Wirkung des Bakteriums Staphylococcus aureus ausblieb. Die Ergebnisse…

Nach einem Schlaganfall muss das Gehirn wieder durchblutet werden – das Blutgerinnsel wird entweder durch Medikamente aufgelöst oder mechanisch entfernt. In seltenen Fällen kann die anschließende Wiederdurchblutung (Reperfusion) jedoch dazu führen, dass die lebenswichtige Blut-Hirn-Schranke zusammenbricht. Wie es dazu kommen kann, haben Wissenschaftler der Universität Maastricht, der…

Nur drei verschiedene Erbgutveränderungen treiben die frühe Entwicklung bösartiger Glioblastome an, fanden Wissenschaftler vom Deutschen Krebsforschungszentrum in einer aktuellen Untersuchung. Bei allen untersuchten Tumoren lag mindestens einer dieser drei Krebstreiber vor. Doch erst eine Aktivierung der Telomerase sorgt schließlich für rasantes Größenwachstum. Bis zu sieben Jahre…

Die „CRISPR/Cas“-Technologie ermöglicht es, Gene gezielt auszuschalten, indem sie DNA an vorab festgelegten Stellen schneidet. Dazu versieht man das Cas-Enzym mit einer Art genetischer Postleitzahl. Mit einer ganzen Bibliothek solcher Postleitzahlen wäre es möglich, in einem einzigen Experiment viele Bereiche der Erbsubstanz parallel prüfen, um beispielsweise festzustellen, welche Gene…

Die meisten kennen es aus der Zahnpasta, aber auch bei der Herstellung neuer Medikamente könnte Fluor bald eine wichtige Rolle spielen. Die Entwicklung und Verbesserung von Pharmazeutika spielt eine zentrale Rolle im fortlaufenden Kampf gegen Krankheiten. Die organische Chemie ermöglicht diesen Fortschritt, indem sie Methoden bereitstellt, mit denen man chemische Strukturen verändern kann. Ein…

Er ist überall und für Menschen mit geschwächtem Immunsystem hochgefährlich. Der Schimmelpilz Aspergillus fumigatus kommt praktisch in allen Lebensräumen der Erde vor: als dunkelgraues, faltiges Polster an feuchten Wänden oder in mikroskopisch kleinen Sporen, die durch die Luft fliegen und auf Tapeten, Matratzen und Fußböden haften. Für gesunde Menschen ist das meist kein Problem –…

Brustkrebs ist die häufigste Krebsart bei Frauen in Deutschland. Dr. Cristina Cadenas, Forscherin am Leibniz-Institut für Arbeitsforschung an der TU Dortmund (IfADo), hat mit ihrem Team einen Mechanismus entdeckt, wie sich Brustkrebszellen selbst mit Nährstoffen versorgen und sich gleichzeitig einen Überlebensvorteil sichern.

Bei der Multiplen Sklerose (MS) überwinden weiße Blutkörperchen („Immunzellen“) die Blut-Hirn-Schranke und wandern in das zentrale Nervensystem ein. Dort greifen sie das körpereigene Nervengewebe an und lösen eine Entzündungsreaktion aus. Wissenschaftler der Universitäten Duisburg-Essen (UDE) und Münster sind der Antwort nun einen Schritt nähergekommen, wie diese eigentlich…

Ein internationales Team von Krebsforschern hat das Tumorerbgut von fast 300 Prostatakrebs-Patienten unter die Lupe genommen. Dabei fanden die Wissenschaftler heraus, dass ein erbgutveränderndes Enzym für die früh auftretenden Mutationen verantwortlich ist. Sie entdeckten außerdem einen möglichen Biomarker, der früh auf aggressiven Verlauf der Erkrankung hinweisen könnte und entwickelten…

Tumorerkrankungen, Infektionen oder schwere Frakturen können die operative Entfernung von Knochen und den Einsatz von Implantaten notwendig machen. Fraunhofer-Forscher haben jetzt in Zusammenarbeit mit europäischen Partnern ein Verfahren entwickelt, mit dem sich Knochenimplantate aus einem speziellen Kunststoff mittels 3D-Druck äußerst passgenau, stabil und variabel herstellen lassen. Der…

Forscherinnen und Forschern der Universität Tübingen und des Deutschen Zentrums für Infektionsforschung (DZIF) ist ein Durchbruch bei der Entschlüsselung multiresistenter Krankheitskeime gelungen. Das Team um Professor Andreas Peschel und Professor Thilo Stehle konnte Struktur und Funktion eines bislang unbekannten Proteins aufklären, mit dessen Hilfe sich gefürchtete Erreger wie…

Wissenschaftler vom Deutschen Krebsforschungszentrum (DKFZ) und vom Heidelberger Institut für Stammzellforschung und experimentelle Medizin (HI-STEM) haben bei Brustkrebs ein zentrales Schalterprotein identifiziert, das bei zellulärem Stress die Metastasierung des Tumors fördert. Der Schalter löst in den Krebszellen ein Stammzell-Programm aus, das die aggressive Ausbreitung begünstigt. Auch…

Bei der Multiplen Sklerose wird das Hirngewebe von einer fehlgeleiteten Antwort des körpereigenen Abwehrsystems geschädigt. Bei der Entstehung der Krankheit könnten bakterielle Darmbewohner eine viel grössere Rolle spielen als bisher angenommen, wie Forschende der Universität Zürich in ihren Arbeiten zeigen.

Ein Forschungsteam der ETH Zürich und des Kinderspitals Zürich haben ein neu entwickeltes Korrekturwerkzeug angewandt, um Gen-Mutationen gezielt zu korrigieren. Damit heilten die Wissenschaftler Mäuse, die an einer vererbbaren Stoffwechselkrankheit litten, die auch Menschen betrifft.

Forscher haben das Protein Nurr1 so modifiziert, dass es von außen in Zellen eindringen kann. Eine Fehlfunktion des Proteins kann unter anderem eine Ursache der Parkinson-Krankheit sein. Nurr1 wird schon länger als möglicher Ansatzpunkt für die Parkinson-Therapie diskutiert, ist in seiner normalen Form aber nicht brauchbar, da es nicht in Zellen gelangen kann. Ein Team der Ruhr-Universität…

Bei der Analyse von großen Mengen an genetischen Krebsdaten, haben Wissenschaftler der ETH Zürich bisher unerforschte molekulare Veränderungen gefunden. Diese könnten helfen neue personalisierte Krebstherapien zu entwickeln.

Patienten mit CDDs (congenital diarrheal disorders), einer Gruppe seltener, weitgehend unerforschter Erbkrankheiten, leiden häufig bereits bei der Geburt an schweren, oft lebensbedrohlichem Durchfall. Wissenschaftler haben nun die molekularen Mechanismen der Erkrankungen erforscht. Dabei sind sie auf ein Protein gestoßen, das eine entscheidende Rolle in der Fettverdauung spielt.

Für die Behandlung von Patienten mit einer bestimmten Form von Blutkrebs gibt es seit kurzem ein neues Medikament, welches die bisherige Chemotherapie durch eine Immunabwehrtherapie ersetzt, die viel weniger Nebenwirkungen hat. Allerdings bindet sich das Medikament auch an die roten Blutzellen. Das führt zu zahlreichen Problemen.

Sie ist sehr selten und gilt bislang als unheilbar: die Stoffwechselkrankheit Multiple Sulfatasedefizienz (MSD). Eine Therapie für MSD zu entwickeln, ist Ziel biochemischer Forschung. In ihrer aktuellen Studie sind Wissenschaftler der Universität Bielefeld und des Universitätsklinikums Göttingen diesem Ziel einen Schritt näher gekommen. Ihnen ist es gelungen, molekulare Faktoren zu…

Die auch als "Krankenhauskeime" bekannten multiresistenten Bakterien stehen zunehmend im Fokus der öffentlichen Aufmerksamkeit. In Kliniken stellen sie eine große Gefahr dar, vor allem für immunsupprimierte Patienten. Wissenschaftler der Technischen Universität (TU) Berlin haben jetzt in Zusammenarbeit mit der französischen Firma Deinove eine neue Klasse von Lipopeptid-Antibiotika…

Den ungleichen Kampf zwischen Antibiotika und resistenten Bakterien haben jetzt ein internationales Forscherteam sichtbar gemacht. Im Röntgenlaser des SLAC National Accelerator Laboratory in Stanford zeigt sich, wie die Erreger den Wirkstoff gezielt abtöten. Die Wissenschaftler versprechen sich davon mehr als nur spektakuläre Bilder - die Aufnahmen sollen auch dazu beitragen, die…

Bluthochdruck hat nicht immer mit dem Lebensstil zu tun. Bei einem Teil der Hochdruck-Patienten, ist ein Tumor in der Nebenniere dafür verantwortlich, dass die Blutgefäße unter Spannung stehen. Viele von ihnen könnten durch eine Operation dauerhaft geheilt werden. Mithilfe innovativer Bildgebung kann die Behandlung des hormonell bedingten Bluthochdrucks, auch Conn-Syndrom genannt, verbessert…

Egal ob Staphylokokken oder MRSA-Keime: Resistente Bakterien sind weltweit ein Problem. Neue Wirkstoffe mit geringen Nebenwirkungen sind nötig, um Infektionskrankheiten langfristig und verlässlich behandeln zu können. Ihre Erforschung ist aber aufwendig, teuer. Ein neues Projekt der Martin-Luther-Universität Halle-Wittenberg (MLU), der Universität Greifswald und der Universität Würzburg…

LMU-Forscher weisen erstmals nach, welchen Einfluss die innere Uhr bei Atherosklerose hat. Ihre Studie gibt einen entscheidenden Hinweis, wie sich therapeutische Ansätze verbessern lassen.

Ein Forscher-Team unter Beteiligung des Deutschen Zentrums für Diabetesforschung (DZD) hat einen neuen Botenstoff identifiziert, der das Entstehen von Insulinresistenz sowie chronischen Entzündungen begünstigt. Er wird bei starkem Übergewicht aus den Fettzellen des Bauchfetts freigesetzt und ans Blut abgegeben. Details wurden im Fachmagazin "Diabetologia" veröffentlicht. Die…

Forschende des Inselspitals, der Universität Bern sowie der Universität Barcelona haben entdeckt, wie die Produktion von spezifischen menschlichen Sexualhormonen, sogenannten Androgenen, unterbrochen wird. Die Erkenntnisse können dazu beitragen, neue Therapieansätze zu entwickeln, da eine Überproduktion dieser Androgene zu Krankheiten wie Prostatakrebs oder dem polyzystischen…

Seit gut drei Jahren ist die Anzahl der mit MRSA besiedelten und erkrankten Patienten in Deutschland rückläufig. Dank intensiver Anstrengungen konnte diese Trendwende nach einem kontinuierlichen Anstieg der Fälle seit dem Jahr 2000 erreicht werden. Dennoch, so wurde auf der 70. Jahrestagung der Deutschen Gesellschaft für Hygiene und Mikrobiologie Mitte Februar in Bochum deutlich, kann bei den…

Erhöhte Werte bestimmter Lipide im Gehirn könnten frühe Anzeichen von Parkinson sein, davon geht eine Studie des McLean Hospital und der University of Oxford aus. Die in "Neurobiology of Aging" veröffentlichten Ergebnisse könnten erhebliche Auswirkungen auf das Identifizieren von Patienten mit einem Erkrankungsrisiko und der frühen Behandlung von Parkinson haben. Bei Parkinson…

Die Robert-Koch-Stiftung verleiht den mit 120.000 Euro dotierten Robert-Koch-Preis 2018 an Professor Jeffrey V. Ravetch von der Rockefeller University in New York, USA. Mit der Auszeichnung werden seine bahnbrechenden Arbeiten zur Analyse der Antikörper-Antwort gewürdigt. Staffan Normark, Professor am Karolinska-Institut in Stockholm, Schweden, erhält die Robert-Koch-Medaille in Gold für sein…

In einer internationalen Studie haben Wissenschaftlerinnen und Wissenschaftler des Universitätsklinikums Hamburg-Eppendorf (UKE) einen neuen Behandlungsansatz für die spätinfantile Neuronale Ceroid Lipofuszinose (CLN2) – einer Form der sogenannten Kinderdemenz – gefunden. Demnach kann eine Enzymersatztherapie mit Cerliponase alfa den Krankheitsverlauf günstig beeinflussen. Bei rund zwei…

Künstliche Moleküle können nicht nur die Strukturen ihres biologischen Modells nachahmen, sie können sogar ihre Funktionen übernehmen und ihnen Konkurrenz machen. Zu diesem Ergebnis kamen Forscher des CNRS, des Inserm und der Universität Bordeaux. Sie schufen eine künstliche Sequenz, die zum ersten Mal die Oberflächeneigenschaften der DNA nachahmt. Dieses künstliche Molekül ist in der…

Ivan Huc ahmt in seiner Forschung die Prinzipien der Natur nach, und das auf kleinster Ebene. Der Chemiker schafft mit seiner Arbeitsgruppe „Biomimetic Supramolecular Chemistry“ an der Ludwig-Maximilians-Universität München (LMU) künstliche Moleküle, die sich mithilfe einer Art Origami-Technik nach dem Abbild ihrer natürlichen Vorbilder formen lassen, Foldamere nennt er diese. Nun ist es…

Insulinresistenz und erhöhte Blutzuckerspiegel gelten als Ursache eines Typ 2-Diabetes. Doch Wissenschaftler vom Deutschen Krebsforschungszentrum und vom Universitätsklinikum Heidelberg liefern nun Hinweise darauf, dass es sich ganz anders verhalten könnte: An Fliegen zeigen sie, dass erhöhte Spiegel des Stoffwechselprodukts Methylglyoxal die diabetestypischen Entgleisungen des Stoffwechsels…

Bei der Gentherapie bestimmter Erbkrankheiten wird mithilfe bestimmter Transportvehikel, die auch als Genfähren oder Vektoren bezeichnet werden, das therapeutische Gen in die Zielzellen übertragen. Der Gentransfer in blutbildende Stammzellen, die sogenannten hämatopoetischen Stammzellen, wird erfolgreich in klinischen Prüfungen zur Behandlung verschiedener genetischer Erkrankungen erprobt,…

Gentechnisch hergestellte Eiweißstoffe haben zur Jahrtausendwende die Therapie von Rheumaerkrankungen revolutioniert. Sogenannte Biologika konnten bei vielen Patienten das Immunsystem wieder stabilisieren, indem sie gezielt bestimmte entzündungsfördernde Substanzen des Immunsystems abfangen und ausschalten oder ihre Bindungsstellen blockieren. Jetzt ist ein weiterer Meilenstein in der…

Bei jeder Infektion oder Impfung bilden sich Gedächtniszellen, mit denen sich der Körper an den Erreger erinnert. Diese Erkenntnis ist jahrzehntealt – doch strukturell fassen liess sich das zelluläre Immungedächtnis bisher nicht. Forschende von Universität und Universitätsspital Basel haben nun eine mikroanatomische Region in Gedächtniszellen identifiziert, die ein rasches Funktionieren…

Bakterien der Art Pseudomonas aeruginosa weisen häufig Resistenzen gegen gängige Antibiotika auf und zählen zu den Krankenhauskeimen. Sie können alle Organe des Menschen sowie Implantate befallen und in einer dicht zusammengelagerten Gemeinschaft – einem sogenannten Biofilm – lange Zeit im Körper überdauern. Dabei schützt sie der Zusammenhalt im Biofilm vor dem Immunsystem und schirmt…

70 Milliliter pro Schlag, 8.000 Liter am Tag – das sind die beeindruckenden Mengen an Blut, die ein gesundes menschliches Herz täglich durch den Körper pumpt. Gerade bei Älteren ist diese Pumpleitung jedoch oft beeinträchtigt, weil sich das Organ nicht mehr mit ausreichend Blut füllt. Die Betroffenen leiden unter der sogenannten Diastolischen Herzinsuffizienz, einer der häufigsten…

Die Fakultät Life Sciences der Hochschule Rhein-Waal untersuchte Wasch- und Spülmaschinen aus privaten Haushalten auf antibiotikaresistente Keime. Die beruhigende Nachricht: Hinweise auf eine direkte Gesundheitsgefährdung bestehen nicht. Doch man muss auch etwas dafür tun.

Zellalterung, Krebs, Parkinson und Alzheimer - mit freien Sauerstoffradikalen werden meist Krankheiten in Verbindung gebracht. Die Moleküle scheinen jedoch auch positive Aufgaben zu besitzen: Bei Rückenmarksverletzungen spielen sie eine unerlässliche Rolle im Heilungsprozess. Das berichtet ein internationales Forscherteam unter der Leitung von Professor Dr. Simone Di Giovanni vom…

Prof. Dr. Lothar Thomas fordert mehr Information über die neuen Laborparameter bei der Diagnostik und dem Monitoring des Eisenmangels und der Eisensubstitutionstherapie. Eisenmangel und die Eisenmangelanämie sind weltweit verantwortlich für fatale Begleiterkrankungen und werden dennoch allseits unterschätzt. Nach Angaben der Deutschen Gesellschaft für Hämatologie und Medizinische Onkologie…

Am Institut für Pharmakologie der Charité – Universitätsmedizin Berlin haben Wissenschaftler nachgewiesen, dass die Freisetzung von Fettsäuren aus dem Körperfett erhebliche Auswirkung auf die Gesundheit des Herzens hat. Ein Eingriff in den Fettstoffwechsel ermöglichte es ihnen, das Risiko der Entstehung einer Herzschwäche erfolgreich zu senken. Die Ergebnisse der Studie sind in der…

Vitamin D hat eine Sonderstellung unter den Vitaminen: Es wird in unserem Körper selbst hergestellt, genauer gesagt in der menschlichen Haut. Dort entsteht es allerdings nicht von allein: Man braucht dazu das Licht der Sonne. Nur die ultravioletten Strahlen der Sonne sind in der Lage, die in der Haut lagernden Vorstufen von Vitamin D zu aktivieren und in Vitamin D umzusetzen. Dieses Vitamin ist…

Die Entschlüsselung des menschlichen Genoms macht es möglich: Wissenschaftlerinnen und Wissenschaftler können heute potenzielle Erbkrankheiten entdecken, zu denen noch kein Patient bekannt ist. Eine solche Krankheit ist „MPS III-E“, nach ihrem Entdecker ursprünglich auch „Dierks‘sche Krankheit“ genannt. Ärzte im Hadassah-Hebrew University Medical Center in Jerusalem (Israel)…

Ein Wissenschaftlerteam des Helmholtz Zentrums München hat gemeinsamen mit Kollegen der Ludwig-Maximilians-Universität München und einer Forschergruppe der Universität Montpellier, Frankreich, die Strukturen der RNA Polymerase II identifiziert, die für die Termination der Transkription (das Beenden der Abschrift eines Genabschnittes) benötigt werden. Die hierzu durchgeführte genetische…

Genau 200 Jahre nach der Entdeckung des Spurenelements Selen zeigen Forschende am Helmholtz Zentrum München zum ersten Mal, warum dieses chemische Element essenziell für das Überleben von Säugetieren ist. Als Bestandteil des Enzyms GPX4 schützt Selen bestimmte Nervenzellen im Laufe der Entwicklung vor dem Zelltod, berichten die Wissenschaftler im Fachmagazin ‚Cell‘.Vor genau 200 Jahren…

Die Mikrobe des Jahres verzehren wir täglich: als Sauerteigbrot mit Käse oder Salami, im Joghurt oder in Form von Sauerkraut, roter Bete, eingelegten Gurken oder Oliven. Lactobacillus begleitet uns von Geburt an und unterstützt unsere Verdauung, das Immunsystem und sogar unser Wohlbefinden. Die von ihm hergestellte Milchsäure macht Lebensmittel haltbar und dient als Grundlage für abbaubare…

Auf der Suche nach neuen Strategien gegen lebensgefährliche Tuberkulose-Infektionen hat ein Team der Technischen Universität München (TUM), der Harvard University und der Texas A&M University in den USA einen neuen Verbündeten entdeckt: Sie fanden eine Substanz, die den Aufbau der Zellmembran des Bakteriums stört. Es wirkt selbst schon in geringer Konzentration und in Kombination mit…

Der Naturstoff Carolacton wird von im Boden lebenden Mikroorganismen gebildet und hat antibiotische Eigenschaften. Forscher am Helmholtz-Institut für Pharmazeutische Forschung Saarland (HIPS) und am Helmholtz-Zentrum für Infektionsforschung (HZI) fanden jetzt heraus, dass der bakterielle Wirkstoff ein Schlüsselenzym des Folsäurestoffwechsels hemmt. Dieser Stoffwechselweg kommt in den meisten…

Chronische Virusinfektionen wie HIV oder Hepatitis gehören weltweit zu den größten Bedrohungen für die menschliche Gesundheit. Während nach überstandenen akuten Viruserkrankungen meist eine vollständige Genesung und Immunisierung eintritt, gelingt es chronischen Viren das Immunsystem zu umgehen und sich permanent einzunisten.

Wird das Herz durch Sport belastet, gilt das als gesund. Eine Belastung durch Bluthochdruck jedoch macht es krank. Warum ist das so? Und stimmt das immer? Forscher des Deutschen Zentrums für Herz-Kreislauf-Forschung (DZHK) und des Universitätsklinikums Heidelberg haben neue Erkenntnisse gewonnen, wonach ein bislang nicht erkannter Signalweg vor Herzschwäche schützt oder diese auslöst - je…

Antikörper verteidigen unseren Körper gegen Eindringlinge. Die Moleküle bestehen aus Proteinen mit angehängten Zuckern, wobei bisher teilweise unklar war, nach welchem Bauplan letztere angehängt werden. Für die Zeitschrift ‚Nature Communications‘ haben Wissenschaftlerinnen und Wissenschaftler am Helmholtz Zentrum München diesen Bauplan nun im Rechner ergänzt und anschließend im Labor…

Ein Forschungsteam aus Heidelberg, Marburg und Kyoto hat die Struktur der Genomhülle aufgeklärt, mit der das Ebola-Virus seine Erbinformation schützt. Die Wissenschaftlerinnen und Wissenschaftler kombinierten Kristallstrukturstudien und Elektronenmikroskopie, um erstmals die Proteinhülle des Genoms intakter Viren in hoher Auflösung zu rekonstruieren. Die Gruppe veröffentlicht ihre Resultate…

Das Protein Ape1 ist wesentlich an der Regulierung der für die Resistenz verantwortlichen Gene und der Entwicklung von Tumoren beteiligt. Zu diesem Schluss kommen Forscher des zum Nationalen Forschungsrat CNR gehörenden Istituto per il Sistema Produzione Animale in Ambiente Mediterraneo. Diese hatten eine Studie zur Widerstandsfähigkeit von Krebszellen gegen Chemo- und Strahlentherapien…

Über die Sinnhaftigkeit von Brustkrebsscreeningprogrammen tobt seit Jahren ein Streit. Die Befürworter verweisen darauf, dass die frühzeitige Erkennung eines Mammakarzinoms vielen Frauen das Leben rettet. Die Gegner argumentieren, dass der Brustkrebs-Check, vor allem aufgrund von Überdiagnostik, mehr Schaden anrichtet, als er verhindert. Seit Kurzem aber taucht in der Diskussion immer…

Botenstoffe, die bei Fettleibigkeit ins Blut abgegeben werden, beeinflussen den Stoffwechsel von Brustkrebszellen, die dadurch aggressiver werden, berichten Wissenschaftlerinnen und Wissenschaftler des Helmholtz Zentrums München, der Technischen Universität München (TUM) und des Universitätsklinikums Heidelberg. Das Team konnte den Mechanismus bereits durch einen Antikörper unterbrechen.

Magenkrebs zählt zu den fünf tödlichsten Krebsarten: Jährlich sterben etwa 750.000 Patienten an dieser Erkrankung, so die Statistik der Weltgesundheitsorganisation WHO. Als Hauptauslöser gilt das Bakterium Helicobacter pylori (H. pylori). Wirkungsvolle Therapien gegen Magenkrebs gibt es derzeit nicht, zunehmende Antibiotikaresistenzen erschweren die Behandlung der Infektion zusätzlich.…

Wissenschaftler der Charité – Universitätsmedizin Berlin haben ein Enzym identifiziert, das die Verwertung von Glukose in Leberzellen maßgeblich beeinflusst. Das Enzym Retinol-Saturase unterstützt die Zellen dabei, sich an variierende Zuckerkonzentrationen anzupassen.

Wissenschaftler der Medizinischen Hochschule Hannover haben zusammen mit Kollegen des Universitätsklinikums Hamburg-Eppendorf einen wichtigen Schalter der Immunabwehr gefunden und charakterisiert: das Enzym MK2, das eine entscheidende Rolle bei Leben und Tod von Zellen spielt.

Ein internationales Team von Wissenschaftlern vom Deutschen Krebsforschungszentrum und von der Universität Zürich hat jetzt gezeigt, dass chronischer Zelltod die Tumorentstehung begünstigt.

Mit einem Kaugummi frühzeitig eine Entzündung im Mund erkennen: Ein Forschungsteam der Universität Würzburg präsentiert diese Neuerung in der Zeitschrift „Nature Communications“.

Wissenschaftler der Medizinischen Hochschule Hannover (MHH) haben im Mausmodell einen neuen Ansatz für die Therapie der diastolischen Herzschwäche entdeckt: Die Herzfunktion verbesserte sich, wenn sie eine bestimmte sogenannte „lange nichtkodierende RNA“ (lncRNA) hemmten.

Die Robert-Koch-Stiftung verleiht den mit 120.000 Euro dotierten Robert-Koch-Preis 2017 zu gleichen Teilen an die Professoren Rafi Ahmed, Emory University und Emory Vaccine Center, Atlanta, USA, und Antonio Lanzavecchia, Institute for Research in Biomedicine, Università della Svizzera italiana, Bellinzona, und ETH Zürich, Schweiz. Mit dem Preis werden die bahnbrechenden Forschungsarbeiten…

Wasser schmeckt selten sauer. Aber gerade die Rezeptoren für diese Geschmacksrichtung, signalisieren dem Trinkenden: „Was jetzt über die Zunge strömt, ist Wasser.“ Das haben erstmals Wissenschaftler des Instituts für Anatomie der Medizinischen Fakultät der Universität Duisburg-Essen (UDE) zusammen mit Kollegen des California Institute of Technology nachgewiesen.

Der Austausch eines einzigen Aminosäure-Bausteins in einem Stoffwechselenzym kann Ursache für verschiedene Arten von Krebs sein. Wissenschaftler aus dem Deutschen Krebsforschungszentrum und dem Universitätsklinikum Heidelberg konnten in Zusammenarbeit mit der Firma Bayer nun einen Wirkstoffkandidaten entwickeln, der spezifisch das veränderte Enzym blockieren soll. Erste präklinische Studien…

Laborversuche und Daten aus Untersuchungen von Menschen mit Schizophrenie deuten auf neue Möglichkeiten der Diagnose und individualisierten Behandlung hin. Dabei geht es um die Messung der Konzentration eines an der Genregulation beteiligten Proteins im Blut und darum, dessen Aktivität medikamentös zu beeinflussen.

Mittels Hyperpolarisations-MRT, die um ein Vielfaches sensitiver ist als die klassische Kernspintomographie, lassen sich Stoffwechselvorgänge im Organismus abbilden. Ein Forschungsteam aus Deutschland hat das Verfahren nun wesentlich vereinfacht.

Eine Forschungsgruppe der Max F. Perutz Laboratories, einem Joint Venture der Universität Wien und der Medizinischen Universität Wien, hat gemeinsam mit anderen WissenschafterInnen aus Australien und Kanada ein neues bioinformatisches Werkzeug zum Vergleich von Genomdaten entwickelt. Das Programm „ModelFinder“ verwendet einen schnellen Algorithmus, der bisher nicht verfügbare Einsichten in…

Bakterielle Infektionen stellen eine enorme globale Bedrohung dar, weltweit nimmt die Verbreitung von Bakterienstämmen zu, die gegen gängige Antibiotika resistent sind. Forscher hoffen, neuartige Therapien zu finden, indem sie die Wechselwirkung zwischen Erreger und Wirt im Detail verstehen lernen. Nun haben Wissenschaftler der Goethe-Universität am Beispiel der Salmonellen-Infektion einen…

Forscher der Universität Graz haben die Struktur des Enzyms Relaxase entschlüsselt, das mithilft, DNA zwischen Bakterien auszutauschen. Durch diesen Vorgang können ganze Populationen von Krankheitserregern binnen kürzester Zeit gegen verschiedene Antibiotika resistent werden.

Eine internationale Forschergruppe mit dem Bayreuther Biochemiker Prof. Dr. Clemens Steegborn präsentiert in 'Science' neue, für die Biomedizin wegweisende Forschungsergebnisse zur Rolle des Moleküls NAD⁺ bei der Korrektur von Schäden am Erbgut.

Schon eine niedrige Dosis des im Tabakrauch enthaltenen Umweltgiftes Benzpyren schädigt die DNA. Wie Wissenschaftler des Instituts für Toxikologie an der Universitätsmedizin Mainz nun erstmalig nachgewiesen haben, können sich die geschädigten Zellen jedoch an diesen Schaden anpassen. Allerdings geht diese Anpassung mit einem erhöhten Mutationsrisiko der Zellen einher.

Wissenschaftler am Klinikum der Universität München sowie den Universitäten Newcastle und Liverpool haben in Zusammenarbeit mit internationalen Kollegen eine Genmutation identifiziert, die zu einer angeborenen Muskelerkrankung führt. Die Ergebnisse der Studie sind im Februar 2017 in der Online-Ausgabe der Zeitschrift "American Journal of Human Genetics" veröffentlicht worden.

Um inaktive Immunzellen zu infizieren, muss das HI-Virus große Hürden überwinden. Ein internationales Forscherteam hat einen neuen Abwehrmechanismus dieser Zellen identifiziert. Dies könnte helfen, effektivere HIV-Therapien zu entwickeln.

Ob Menschen Rechts- oder Linkshänder werden, bestimmt nicht das Gehirn, sondern das Rückenmark. Diese Schlussfolgerung legen Ergebnisse eines Teams um Privatdozent Dr. Sebastian Ocklenburg, Judith Schmitz und Prof. Dr. Dr. h. c. Onur Güntürkün nahe. Die Biopsychologen der Ruhr-Universität Bochum wiesen mit Kollegen aus den Niederlanden und Südafrika nach, dass die Genaktivität im…

Jeder Tumor erhält bei seiner Entstehung ein spezifisches genetisches Profil, das sich für die personalisierte Krebstherapie nutzen lässt. Doch selbst innerhalb ein und desselben Tumors entwickeln sich Regionen mit unterschiedlicher genetischer Ausstattung. Mit Hilfe eines dreidimensionalen Tumormodells konnten Wissenschaftler im Deutschen Konsortium für Translationale Krebsforschung (DKTK)…

Das Protein CD44v6 spielt eine wesentliche Rolle bei der Metastasierung von Tumoren. Wissenschaftler am Karlsruher Institut für Technologie (KIT) haben nun eine Möglichkeit entdeckt, CD44v6 exprimierende Krebszellen aufzuspüren, durch fluoreszierende Nanokristalle.

Biokompatible Nano-Kapseln, beladen mit einer Aminosäure und bestückt mit einem Enzym, vereinen jetzt zwei Anti-Tumor-Strategien zu einem synergistischen Therapiekonzept, von dem sich Forscher eine stärkere Wirkung bei minimierten Nebenwirkungen erhoffen. Das Wirkprinzip: Tumorzellen wird ihr Nährstoff Glucose entzogen, indem er in toxisch wirkendes Stickstoffmonoxid (NO) und…

Infektionen mit Helicobacter pylori beeinflussen die mikrobielle Vielfalt in Mund und Dünndarm. Eine Infektion kann Magenkrebs verursachen. Eine Infektion mit dem Keim führt bei allen Betroffenen zu chronischen Magenschleimhautentzündungen, bei einem Teil der Infizierten zu Magenkrebs. Um das Zusammenspiel von Helicobacter mit der natürlich vorkommenden Mikroorganismengemeinschaft im oberen…

Eine bisher als unbehandelbar geltende Untergruppe von Lungentumoren reagiert extrem empfindlich auf eine kürzlich zugelassene Gruppe von Krebsmedikamenten.

Forscher haben bei Legionellen einen neuen Ubiquitinierungs-Mechanismus entdeckt, der die pathogenen Effekte von Bakterien erklärt. Ivan Dikic und sein Team an der Goethe-Universität vermuten, dass er auch an vielen anderen biologischen Prozessen beteiligt ist.

Ein internationales Team von Wissenschaftlern und Klinikern hat erstmals europaweit die Ausbreitung von besonders gefürchteten multiresistenten Enterobakterien untersucht und vergleichbare Daten erhoben. Im Fokus der Studie stehen Klebsiella pneumoniae und Escherichia coli: Darmbakterien, die immer häufiger gegen das Reserveantibiotikum Carbapenem resistent sind.

Auf Patienten übertragen, was man zuvor in der tierexperimentellen Untersuchung festgestellt hat – das ist das große Ziel vieler in der Biomedizin arbeitender Wissenschaftler. Gelungen ist es Forschern des Exzellenzclusters "Cells in Motion" (CiM) der Universität Münster: Sie konnten erstmals akute Entzündungen im Gehirn bei Patienten mit Multipler Sklerose (MS) bildgebend…

Biochemiker der Medizinischen Fakultät Mannheim der Universität Heidelberg haben eine wegweisende Entdeckung gemacht, die eine bislang kaum erforschte Ebene der Genregulation in den Fokus rückt. Das Forscherteam um Prof. Georg Stoecklin entdeckte einen Schalter, über den die Zelle quasi die gesamte Boten-RNA (mRNA) innerhalb kürzester Zeit eliminieren kann. mRNAs sind die Abschriften von…

In Deutschland sterben bis zu 15.000 Patienten im Jahr an Krankenhausinfektionen, so schätzt das Nationale Referenzzentrum für die Überwachung dieser Infektionen. Eine große Rolle spielen hier die multiresistenten Bakterien, denen die gängigen Antibiotika nichts mehr anhaben können. Doch wo kommen diese Keime her? Dieser Frage gingen DZIF-Wissenschaftler von der Uniklinik Köln nach und…
Seegene, Inc., ein Entwickler von Multiplex Real-Time PCR-Technologien gibt die Herausgabe der weltweit ersten automatisierten Entwicklung von in silico basierten Multiplex Real-Time PCR-Assays bekannt.

Schleimig sind sie, doch für Mikroorganismen eine geradezu gemütliche Umgebung: Biofilme. Vor äußeren Einflüssen geschützt, können Bakterien dort ungestört wachsen und Krankheiten auslösen. Wissenschaftlerinnen der Christian-Albrechts-Universität zu Kiel (CAU) erforschen, wie bereits die Entstehung von Biofilmen verhindert werden kann. Darauf basierend könnten Alternativen zu…

Eine neuartige Substanzklasse wirkt sowohl gegen den AIDS-Erreger HIV als auch gegen antibiotikaresistente MRSA-Bakterien. Diese beiden Krankheitserreger treten häufig gemeinsam auf. Künftig – so die Hoffnung der Entdecker – könnten sie mit einem einzigen Medikament bekämpft werden. Wissenschaftler des Helmholtz-Instituts für Pharmazeutische Forschung Saarland (HIPS) haben sogenannte…

Das Magenkrebs auslösende Bakterium Helicobacter pylori kann sich so genau an den Menschen anpassen, dass es so individuell wird wie ein menschlicher Fingerabdruck: Wie kein anderes Bakterium variiert es dazu im Laufe der Infektion seine Gene. Nun haben Wissenschaftler der Medizinischen Hochschule Hannover (MHH) in Zusammenarbeit mit dem Statistikexperten Dr. Xavier Didelot vom Imperial College…

Bringen Bakterien in den Körper eines Menschen oder eines Tieres ein, werden sie vom Immunsystem als fremd erkannt. Daraufhin versuchen die Immunzellen, diese Fremdkörper zu beseitigen. Wissenschaftler des Helmholtz-Zentrums für Infektionsforschung (HZI) in Braunschweig haben nun gemeinsam mit Kollegen der Universität Umeå in Schweden herausgefunden, wie es Bakterien der Gattung Yersinia…

Biologen haben neue Erkenntnisse zu chronischer myeloischer Leukämie und möglichen Therapieansätzen gewonnen.

Eine von der Klinik und Poliklinik für Chirurgie des Universitätsklinikums Regensburg (UKR) initiierte internationale Studie hat gezeigt, dass Medikamente mit dem Wirkstoff Sirolimus bei Leberkrebs-Patienten nach einer Lebertransplantation zu einer höheren Überlebensdauer führen.

Gegen die zurzeit viel diskutierten „Super-Keime“ wirkt kaum ein Antibiotikum, selbst gegen das bisher als Notfall-Alternative geltende Antibiotikum Colistin sind sie resistent. Derzeit sind neue Antibiotika in der Entwicklung. Diese würden aber die Gefährdungslage nicht ändern können, so Experten im Vorfeld des 13. Kongresses für Infektionskrankheiten und Tropenmedizin in Würzburg.…

Forscher der Universität Bonn und der Ludwig-Maximilians-Universität München haben einen neuen Mechanismus entschlüsselt, wie das Immunsystem spezifisch die Pigmentzellen der Haut angreifen kann. Natürlichen Killerzellen wurde bislang in Abrede gestellt, über ein immunologisches Gedächtnis für das körpereigene Gewebe zu verfügen. Die Forscher wiesen jetzt nach, dass sich diese…